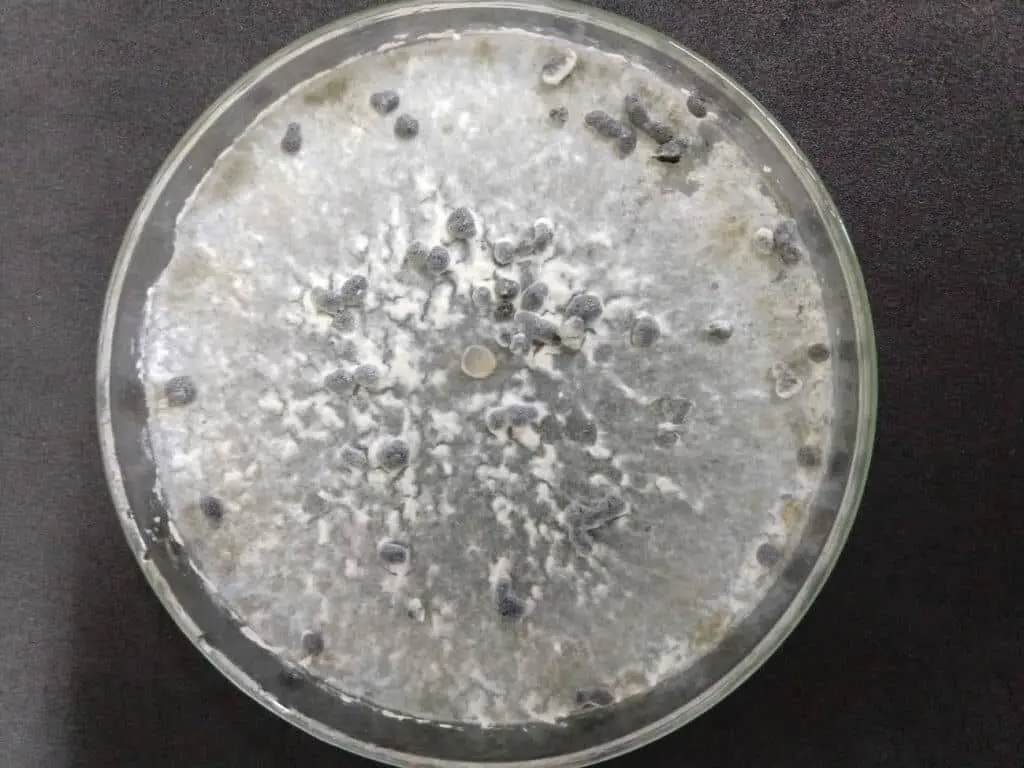

O mofo-branco é uma daquelas doenças que, ano após ano, causam dores de cabeça e prejuízos significativos na lavoura. Esse problema ataca diversas culturas importantes, como soja, feijão, girassol e algodão.
Na soja, por exemplo, o impacto é impressionante: a doença pode levar a perdas de até 70% na produtividade.
Um dos maiores desafios do mofo-branco é que o fungo causador cria estruturas de resistência, chamadas escleródios, que sobrevivem no solo por muitos anos. Por isso, é fundamental tanto evitar que o fungo chegue à sua área quanto saber como manejá-lo corretamente se ele já estiver presente.
Neste guia, vamos detalhar as características da doença, seu ciclo de vida e, o mais importante, as melhores formas de manejo para proteger sua lavoura.
O Que Causa o Mofo-Branco nas Culturas Agrícolas?
O mofo-branco, também conhecido como podridão-de-Sclerotinia, é causado principalmente pelo fungo Sclerotinia sclerotiorum. Ele é um inimigo poderoso, capaz de gerar perdas enormes na produtividade de culturas de grande valor econômico.
O fungo é extremamente versátil, com registros de ataque em mais de 400 espécies de plantas. Basicamente, ele ataca quase tudo, com exceção das gramíneas (como milho, trigo e pastagens). Sua presença é registrada em diversas regiões agrícolas do mundo.
As condições ideais para o mofo-branco são alta umidade e temperaturas amenas. Isso faz com que áreas irrigadas sejam especialmente vulneráveis, pois o ambiente úmido favorece o desenvolvimento do fungo.
Os sintomas são fáceis de reconhecer:
- Inicialmente, surgem lesões com aparência encharcada nas folhas, hastes ou flores.
- Com o avanço da doença, cresce um mofo branco de aspecto algodoado (micélio) sobre essas lesões.
- Depois de um tempo, formam-se os escleródios.
Escleródios: são as estruturas de resistência do fungo, funcionando como “sementes” que garantem sua sobrevivência no solo. São formados por um emaranhado de hifas (filamentos do fungo).
Placa de Petri com crescimento de Scletotinia sclerotiorum, mostrando o micélio branco e os escleródios (pontos pretos).
(Fonte: Arquivo pessoal da autora)
Placa de Petri com crescimento de Scletotinia sclerotiorum, mostrando o micélio branco e os escleródios (pontos pretos).
(Fonte: Arquivo pessoal da autora)
A formação dos escleródios acontece quando os nutrientes no local começam a acabar. Eles têm formato irregular e medem poucos milímetros. No início, são brancos, mas depois se tornam escuros e rígidos, devido ao depósito de melanina, uma substância que os protege.
Esses escleródios são o grande problema, pois podem permanecer vivos no solo por muitos anos. Estudos indicam que eles sobrevivem por até 10 anos, dependendo das condições do ambiente. Isso garante a sobrevivência do fungo na área de cultivo, mesmo durante a entressafra.
Como o S. sclerotiorum se Espalha?
A disseminação do fungo ocorre de várias formas, exigindo atenção redobrada do produtor. Os principais vetores são:
- Sementes Contaminadas: O fungo pode vir junto com as sementes, seja na forma de escleródios misturados ao lote ou como micélio dormente dentro da própria semente.
- Solo Infestado: O solo que já contém escleródios é uma fonte contínua de infecção.
- Máquinas e Implementos Agrícolas: Tratores, colheitadeiras e outros equipamentos sujos com terra de áreas contaminadas podem facilmente transportar o fungo para áreas limpas.
- Água: A água de irrigação ou da chuva pode carregar os escleródios de um ponto a outro da lavoura.
Entender essas formas de disseminação é o primeiro passo para definir as medidas de manejo da doença, como veremos mais adiante.
O Ciclo de Vida do S. sclerotiorum
Para combater o inimigo, é preciso conhecer seu ciclo de vida. Os escleródios presentes no solo podem germinar de duas maneiras diferentes:
1. Germinação Carpogênica (Típica em Soja e Feijão)
Neste processo, o escleródio forma uma estrutura chamada apotécio, que se parece com um pequeno cogumelo de cor alaranjada.
- Apotécio: funciona como uma plataforma de lançamento para os esporos do fungo.
- Dentro do apotécio, são produzidos os ascósporos (esporos), que são liberados no ar.
- O vento carrega esses esporos para outras plantas na mesma área ou em talhões vizinhos, onde eles germinam e iniciam uma nova infecção.
2. Germinação Micelogênica (Comum em Girassol)
Aqui, o escleródio germina diretamente, produzindo hifas (filamentos) que crescem no solo.
- Essas hifas primeiro colonizam a matéria orgânica e depois infectam a parte da planta que está em contato com o solo, como a base do caule.
- Nesse tipo de germinação, não há formação de esporos que são levados pelo vento.
Conhecer esse ciclo ajuda a entender por que certas práticas de manejo, como o uso de palhada, são tão importantes.
 Esquema do ciclo de vida de Sclerotinia sclerotiorum.
(Fonte: Tese Roseli Muniz Giachini adaptado de Wharton e Kirk, 2007)
Esquema do ciclo de vida de Sclerotinia sclerotiorum.
(Fonte: Tese Roseli Muniz Giachini adaptado de Wharton e Kirk, 2007)
Agora, vamos ver como a doença se manifesta em algumas das principais culturas agrícolas.
Mofo-Branco na Cultura da Soja
Na safra 2017/18, o mofo-branco foi um dos grandes vilões da produtividade na região Sul do Brasil. Estima-se que hoje cerca de 10 milhões de hectares de soja no país estejam infestados pelo fungo, com perdas que podem chegar a 70%.
O fungo pode atacar qualquer parte da planta, mas é mais comum nas flores, pecíolos e ramos. Os sintomas começam com manchas encharcadas que se tornam castanhas, cobertas pelo típico mofo branco algodoado. Com o tempo, os escleródios se formam na superfície e também dentro das hastes e vagens.
A fase de maior vulnerabilidade da soja é da floração à formação de vagens (estádios R1 a R4).
As sementes infectadas ficam menores, enrugadas e com uma coloração diferente da normal.
 Fungo na soja é capaz de infectar qualquer parte da planta.
(Fonte: Maurício Meyer em Embrapa)
Fungo na soja é capaz de infectar qualquer parte da planta.
(Fonte: Maurício Meyer em Embrapa)
Controle de Mofo-Branco em Soja
O controle químico é uma ferramenta importante, mas sua eficiência depende criticamente do momento da aplicação. O objetivo é proteger as flores e atingir as partes mais baixas da planta e a superfície do solo.
- Primeira Aplicação: Deve ser feita no início do florescimento, no estádio R1 da soja.
- Segunda Aplicação: Realizada cerca de 15 dias após a primeira, para manter a proteção durante o período crítico.
Os principais fungicidas utilizados incluem ingredientes ativos como Fluazinam, Procimidona, Carbendazin e Tiofanato Metílico + Fluazinam. Lembre-se sempre de verificar o registro do produto para a cultura.
Mofo-Branco na Cultura do Feijoeiro
No feijão, o mofo-branco é uma das doenças mais agressivas, com perdas que podem superar 60% se o manejo falhar.
A doença é especialmente problemática durante o florescimento. Os esporos (ascósporos) carregados pelo vento pousam nas pétalas das flores, que são uma excelente fonte de energia para o fungo germinar. Quando essas pétalas caem sobre as folhas, hastes ou no solo, iniciam o ciclo da doença na planta.
Os sintomas são os mesmos: lesões encharcadas de cor castanha, cobertas pelo micélio branco e, posteriormente, a formação de escleródios.
 (Fonte: Revista Cultivar)
(Fonte: Revista Cultivar)
Mofo-Branco na Cultura do Algodão
A doença no algodoeiro é mais comum em áreas irrigadas, principalmente quando há cultivo de soja ou feijão na rotação. Climas com temperatura amena e alta umidade também criam o cenário perfeito para o fungo.
Os sintomas aparecem nas folhas, hastes e maçãs, geralmente começando na parte de baixo da planta (baixeiro). Surgem lesões aquosas que desenvolvem o mofo branco, seguido pela formação de escleródios. Durante a floração, a disseminação é mais rápida, pois as flores servem de alimento para o fungo.
Mofo-Branco na Cultura do Girassol
No girassol, a doença é chamada de podridão branca e é considerada o problema mais sério para a cultura em nível mundial. Se o ataque ocorrer na fase de plântula, pode causar a morte e criar falhas no estande.
A doença pode se manifestar de três formas diferentes:
- Podridão basal: A planta murcha e surge uma lesão marrom e mole na base do caule. Com umidade, o micélio branco aparece.
- Podridão no meio da haste: Os sintomas são parecidos, com escleródios se formando dentro e fora da haste.
- Podridão do capítulo: Começa com lesões pardas e encharcadas na flor (capítulo). O fungo pode destruir toda a estrutura floral e formar muitos escleródios em seu interior.
Mofo-Branco na Cultura do Amendoim
A doença no amendoim pode ser causada tanto pelo S. sclerotiorum quanto pelo Sclerotinia minor. As perdas podem passar de 50%. Os sintomas seguem o padrão: lesões encharcadas que, em períodos úmidos, desenvolvem o micélio branco e os escleródios.
Mofo-Branco na Cultura da Canola
Também conhecida como podridão branca, é uma das principais doenças da canola no Brasil. Os sintomas são um apodrecimento seco no caule e na haste. Com o avanço, os tecidos ficam marrons, cobertos pelo mofo branco e com escleródios. Plantas atacadas perdem folhas, amadurecem antes da hora e podem produzir sementes chochas.
Medidas de Manejo do Mofo-Branco
O controle do mofo-branco é difícil, pois o fungo produz estruturas de resistência (escleródios) e ataca muitas culturas. Portanto, a primeira regra é: evite a entrada do fungo na sua área.
Até o momento, não existem variedades totalmente resistentes. O que temos são cultivares com resistência parcial. O manejo deve ser integrado, combinando várias estratégias.
Lembre-se: os fungicidas possuem registros específicos para cada cultura. Verifique sempre antes de usar.
Medidas Preventivas (Barreiras de Entrada)
- Use Sementes Sadias e Certificadas: Essa é a principal porta de entrada. Exija sementes livres de escleródios e de micélio interno.
- Limpeza de Máquinas e Equipamentos: Limpe colheitadeiras, tratores e implementos ao mudar de um talhão contaminado para um limpo.
 Sementes de soja com escleródio (estrutura escura e irregular).
(Fonte: A Granja)
Sementes de soja com escleródio (estrutura escura e irregular).
(Fonte: A Granja)
Práticas Culturais (Manejo do Ambiente)
- Rotação de Culturas com Gramíneas: Cultive espécies que não são hospedeiras, como milho, sorgo ou pastagens, para quebrar o ciclo do fungo.
- População de Plantas Adequada: Evite plantios muito adensados. Espaçamentos maiores melhoram a aeração e reduzem a umidade, desfavorecendo o fungo.
- Cultivo sobre Palhada de Gramíneas: A palha funciona como uma barreira física, dificultando a germinação dos escleródios e o contato do fungo com a planta.
- Escolha da Época de Plantio: Se possível, evite que os estágios mais vulneráveis da cultura (como a floração) coincidam com períodos de alta umidade.
- Escolha de Cultivares: Prefira variedades com arquitetura de planta mais “aberta”, que permite maior circulação de ar.
- Sistema de Plantio Direto: Pode reduzir a incidência da doença ao dificultar o contato da planta com o solo contaminado.
Controle Direto (Ações Específicas)
- Tratamento de Sementes: Use fungicidas específicos para proteger as sementes e plântulas nos estágios iniciais.
- Controle Biológico: Existem microrganismos antagonistas, como o Trichoderma, que podem ser usados para controlar o S. sclerotiorum.
- Controle Químico (Fungicidas): Aplique fungicidas de forma preventiva nos momentos de maior risco, conforme a recomendação para cada cultura.
- Eliminar Plantas Invasoras: Muitas plantas daninhas também são hospedeiras do fungo e devem ser controladas.
Para consultar os produtos registrados, acesse o site do Agrofit. Para a recomendação de produtos e doses, procure sempre um Engenheiro Agrônomo.
Eficiência de Fungicidas para Controle do Mofo-Branco
A Embrapa realiza pesquisas constantes sobre a eficiência de fungicidas. Os resultados abaixo, da safra 2017/18 para a soja, podem ajudar na escolha do produto mais adequado.
Ao analisar a tabela, compare sempre os resultados dos tratamentos com a “Testemunha”, que é a área que não recebeu aplicação de fungicida.
 Resultados de ensaios cooperativos de controle de mofo-branco em soja (safra 2017/18), mostrando incidência, controle, produtividade e outros parâmetros.
(Fonte: Embrapa)
Resultados de ensaios cooperativos de controle de mofo-branco em soja (safra 2017/18), mostrando incidência, controle, produtividade e outros parâmetros.
(Fonte: Embrapa)
Lembre-se que a melhor medida de manejo é a prevenção.
Para um manejo realmente eficaz, você deve combinar várias dessas medidas. A chave do sucesso está em integrar as práticas de manejo!
Conclusão
O mofo-branco é um adversário sério para diversas culturas agrícolas, capaz de causar grandes perdas de produtividade.
Neste artigo, vimos os principais sintomas, o ciclo de vida do fungo, as condições que o favorecem e como ele se espalha. Também detalhamos diversas estratégias de manejo, que devem ser usadas de forma integrada para um controle efetivo.
Lembre-se sempre: a prevenção da entrada do fungo na sua área é a melhor e mais barata estratégia!
Com essas informações em mãos, você está mais preparado para proteger sua produção. Bom manejo
Glossário
Apotécio: Estrutura reprodutiva em forma de taça ou pequeno cogumelo, que se desenvolve a partir de um escleródio. É responsável por produzir e liberar os esporos (ascósporos) que infectam as plantas pelo ar.
Ascósporos: Esporos microscópicos do fungo, liberados pelo apotécio. Funcionam como “sementes” que são transportadas pelo vento e, ao pousarem nas flores ou folhas, iniciam a infecção da doença.
Entressafra: Período entre a colheita de uma safra e o plantio da safra seguinte. Para o mofo-branco, este é o período em que as estruturas de resistência (escleródios) sobrevivem no solo, aguardando condições favoráveis para germinar.
Escleródios: Estruturas de resistência do fungo, de cor escura e aspecto rígido, formadas por um emaranhado de filamentos (hifas). São a principal forma de sobrevivência do mofo-branco no solo, podendo permanecer viáveis por mais de 10 anos.
Germinação Carpogênica: Tipo de ciclo do fungo em que o escleródio no solo germina e forma um apotécio. Este, por sua vez, libera ascósporos no ar, que são a principal fonte de infecção para culturas como soja e feijão.
Micélio: Parte vegetativa do fungo, visível como uma massa de filamentos brancos e de aspecto algodoado sobre as partes infectadas da planta. É o sintoma mais característico que dá o nome de “mofo-branco” à doença.
Sclerotinia sclerotiorum: Nome científico do fungo causador da doença conhecida como mofo-branco ou podridão-de-Sclerotinia. É um patógeno que ataca uma vasta gama de culturas, com exceção das gramíneas.
Como simplificar o controle do mofo-branco e proteger seu lucro
O manejo integrado do mofo-branco, como vimos, envolve uma série de estratégias que precisam ser coordenadas com precisão, desde a rotação de culturas até a aplicação de fungicidas na janela correta. Controlar todas essas frentes e, ao mesmo tempo, entender o impacto financeiro de cada decisão é um dos maiores desafios do produtor.
É aqui que a tecnologia se torna uma grande aliada. Um software de gestão agrícola como o Aegro permite planejar e registrar todas as atividades no campo, garantindo que as pulverizações sejam feitas no momento ideal para máxima eficácia. Além disso, o sistema conecta essas operações aos custos de produção, mostrando exatamente quanto está sendo investido no controle da doença e ajudando a avaliar se o tratamento está valendo a pena.
Que tal tomar decisões mais seguras e rentáveis na sua fazenda?
Experimente o Aegro gratuitamente e veja na prática como é fácil ter o controle total da sua lavoura.
Perguntas Frequentes
Por que a rotação de culturas com gramíneas como milho e sorgo é tão importante para o manejo do mofo-branco?
A rotação com gramíneas é crucial porque o fungo Sclerotinia sclerotiorum não ataca essas plantas. Ao cultivar uma cultura não hospedeira, você interrompe o ciclo de vida do fungo, fazendo com que muitos escleródios (suas estruturas de resistência) percam a viabilidade no solo por falta de alimento, reduzindo a pressão da doença para a safra seguinte.
É possível eliminar completamente os escleródios do solo uma vez que a área está infestada?
Não, atualmente não é possível erradicar 100% dos escleródios de uma área infestada, pois eles podem sobreviver no solo por mais de 10 anos. O objetivo do manejo integrado é reduzir a quantidade e a viabilidade dessas estruturas a níveis que não causem danos econômicos, combinando diversas práticas de controle.
Qual é o período mais vulnerável da soja ao mofo-branco e quando devo aplicar fungicidas?
O período de maior risco para a soja é durante a fase reprodutiva, especialmente da floração (estádio R1) até a formação de vagens (R4). As aplicações de fungicidas devem ser preventivas, com a primeira recomendada no início do florescimento (R1), visando proteger as flores, que são a principal porta de entrada para o fungo.
Como a palhada no sistema de plantio direto ajuda a controlar o mofo-branco?
A palhada de gramíneas atua como uma barreira física sobre o solo. Ela dificulta a germinação dos escleródios e o desenvolvimento dos apotécios (estruturas que liberam os esporos no ar). Além disso, a cobertura do solo ajuda a criar um microclima menos úmido na base da planta, desfavorecendo a infecção.
Além das sementes contaminadas, qual outra fonte de disseminação do mofo-branco merece atenção especial?
A limpeza de máquinas e implementos agrícolas é fundamental. Tratores e colheitadeiras que operam em áreas contaminadas podem facilmente transportar terra com escleródios para talhões limpos. A limpeza cuidadosa dos equipamentos antes de mudar de área é uma das principais medidas para evitar a entrada da doença.
Existem variedades de soja ou feijão totalmente resistentes ao mofo-branco?
Atualmente, não existem variedades comerciais que sejam completamente imunes ao mofo-branco. O que há no mercado são cultivares com diferentes níveis de tolerância ou resistência parcial, que podem adoecer menos ou sofrer menores perdas de produtividade. A escolha de um cultivar adequado deve ser parte de um manejo integrado, e não uma solução isolada.
Artigos Relevantes
- Todas as orientações para tratamento de sementes de soja: Este artigo é o complemento prático ideal, pois aprofunda uma das principais medidas preventivas citadas no guia principal: o uso de sementes sadias. Ele detalha o ‘como fazer’ do tratamento de sementes, abordando a escolha de produtos (inclusive para Sclerotinia) e os métodos de aplicação, transformando uma recomendação teórica em uma ação concreta e bem-informada para o produtor.
- Fungicidas da cultura da soja que já apresentam resistência e alternativas de controle: Enquanto o artigo principal menciona o controle químico, este candidato explora o maior risco associado a ele: a resistência. Ele fornece o contexto estratégico crucial, explicando por que o manejo integrado e a rotação de fungicidas são indispensáveis, não apenas para o mofo-branco, mas para a sustentabilidade da lavoura. Isso reforça a mensagem principal sobre a importância de não depender de uma única ferramenta.
- O que são fungicidas multissítios e por que você deve passar a utilizá-los: Este artigo funciona como uma continuação direta da discussão sobre resistência, apresentando uma solução técnica avançada. Ele explica o mecanismo dos fungicidas multissítios, uma ferramenta essencial para proteger a eficácia dos produtos sítio-específicos mencionados no artigo principal. Agrega um valor técnico imenso, ensinando ao leitor uma estratégia moderna para potencializar o controle químico de forma mais duradoura.
- Cultura da soja no Brasil: Guia Completo do Plantio à Industrialização: Este guia completo fornece o panorama geral onde o problema do mofo-branco se insere. Ele detalha práticas de manejo cultural, como rotação de culturas e plantio direto, que são fundamentais para o controle do mofo-branco. O artigo principal recomenda essas práticas, e este candidato explica sua importância e implementação no contexto de todo o sistema de produção da soja, oferecendo uma base de conhecimento sólida.
- Tudo o que você precisa saber sobre Macrophomina em soja: Este artigo complementa o principal ao apresentar um estudo de caso sobre outra doença de solo de difícil controle que forma estruturas de resistência. Ao discutir a podridão de carvão (Macrophomina), ele reforça a mensagem central de que o manejo preventivo e integrado é a melhor estratégia contra patógenos de solo. A comparação entre as duas doenças, que prosperam em condições distintas, enriquece o entendimento do leitor sobre a saúde do solo de forma holística.

